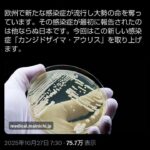

- 1 名前:ここからは表現の自由でイカせていただきます 投稿日時:2025/10/30(木) 14:37:49.220 ID:dqdTlw7cj
- https://x.com/YUUNA_BURUBESUM/status/1983747169783071168/
@YUUNA_BURUBESUM
こういう都内のウサギ小屋みたいな狭い家で一生懸命オシャレにしようとしてる人見るとマジで見てて恥ずかしくなるし切ない…
普通の散らかった部屋よりも見てて痛々しい… - 2 名前:ここからは表現の自由でイカせていただきます 投稿日時:2025/10/30(木) 14:37:56.506 ID:dqdTlw7cj
- 草
- 3 名前:ここからは表現の自由でイカせていただきます 投稿日時:2025/10/30(木) 14:38:02.412 ID:dqdTlw7cj
- やめたれよ…
- 4 名前:ここからは表現の自由でイカせていただきます 投稿日時:2025/10/30(木) 14:38:35.871 ID:dqdTlw7cj
- こんなこと言ったら傷つくよ?なんでそんなこというの
- 5 名前:ここからは表現の自由でイカせていただきます 投稿日時:2025/10/30(木) 14:38:50.073 ID:dqdTlw7cj
- もっと思いやりを持とうよ
- 6 名前:ここからは表現の自由でイカせていただきます 投稿日時:2025/10/30(木) 14:38:50.191 ID:9WM4qk8lh
- 綺麗にするのはええことやないか
- 7 名前:ここからは表現の自由でイカせていただきます 投稿日時:2025/10/30(木) 14:39:41.781 ID:F.IKVLeQs
- 名古屋ゲェジ
- 8 名前:ここからは表現の自由でイカせていただきます 投稿日時:2025/10/30(木) 14:39:46.734 ID:SyVUKbyAn
- 田舎で軽自動車乗ってそう
- 9 名前:ここからは表現の自由でイカせていただきます 投稿日時:2025/10/30(木) 14:40:08.433 ID:dqdTlw7cj
- 消せ
- 10 名前:ここからは表現の自由でイカせていただきます 投稿日時:2025/10/30(木) 14:40:14.168 ID:dqdTlw7cj
- 消せ消せ
- 11 名前:ここからは表現の自由でイカせていただきます 投稿日時:2025/10/30(木) 14:40:16.839 ID:kH9RRIUWk
- なんで二枚目のいいねとリツイート切り抜いてるの?
- 16 名前:ここからは表現の自由でイカせていただきます 投稿日時:2025/10/30(木) 14:40:37.893 ID:F.IKVLeQs
- >>11
自演だからね - 82 名前:ここからは表現の自由でイカせていただきます 投稿日時:2025/10/30(木) 14:50:10.162 ID:YCyrEAFvC
- >>11
たれw - 13 名前:ここからは表現の自由でイカせていただきます 投稿日時:2025/10/30(木) 14:40:20.361 ID:ttm/95xsl
- 1LDKはないと人間の住処ではない
- 14 名前:ここからは表現の自由でイカせていただきます 投稿日時:2025/10/30(木) 14:40:20.860 ID:dqdTlw7cj
- 消せ消せ消せ消せ
- 15 名前:ここからは表現の自由でイカせていただきます 投稿日時:2025/10/30(木) 14:40:29.657 ID:dqdTlw7cj
- 消せ消せ消せ消せ消せ消せ
- 17 名前:ここからは表現の自由でイカせていただきます 投稿日時:2025/10/30(木) 14:40:44.233 ID:0vCs.hcDK
- こんな過疎ツイートどこから見つけてくるんや
自分でツイートしたんか - 18 名前:ここからは表現の自由でイカせていただきます 投稿日時:2025/10/30(木) 14:40:47.953 ID:dqdTlw7cj
- うるさい!東京はキラキラしてるんだよ!!!
- 19 名前:ここからは表現の自由でイカせていただきます 投稿日時:2025/10/30(木) 14:41:15.223 ID:F.IKVLeQs
- これで東京叩いてもらえると思ってるのどうかしてるよ
- 20 名前:ここからは表現の自由でイカせていただきます 投稿日時:2025/10/30(木) 14:41:20.821 ID:5TGZA94q0
- みのるのことかとおもった
- 21 名前:ここからは表現の自由でイカせていただきます 投稿日時:2025/10/30(木) 14:41:22.140 ID:qvpcOvran
- プロジェクター邪魔すぎやろ
- 22 名前:ここからは表現の自由でイカせていただきます 投稿日時:2025/10/30(木) 14:41:31.201 ID:dqdTlw7cj
- >>1
ちなこのXま●こが住んでる家 - 31 名前:ここからは表現の自由でイカせていただきます 投稿日時:2025/10/30(木) 14:42:24.485 ID:qvpcOvran
- >>22
シャチホコ邪魔すぎやろ - 38 名前:ここからは表現の自由でイカせていただきます 投稿日時:2025/10/30(木) 14:43:38.949 ID:I2PY0FDvx
- >>22
部屋広いのはええけどど真ん中にシャチホコはセンスないわ - 39 名前:ここからは表現の自由でイカせていただきます 投稿日時:2025/10/30(木) 14:43:42.864 ID:dqdTlw7cj
- >>22
強すぎw - 42 名前:ここからは表現の自由でイカせていただきます 投稿日時:2025/10/30(木) 14:44:05.864 ID:dqdTlw7cj
- >>22
都民「ギャオオオオオオオオオオン」 - 45 名前:ここからは表現の自由でイカせていただきます 投稿日時:2025/10/30(木) 14:44:14.545 ID:2pa4tRvDe
- >>22
名古屋人らしいセンス - 48 名前:ここからは表現の自由でイカせていただきます 投稿日時:2025/10/30(木) 14:44:37.459 ID:2Sv0ZzQGC
- >>22
シャチホコが気になる - 56 名前:ここからは表現の自由でイカせていただきます 投稿日時:2025/10/30(木) 14:45:36.582 ID:fgWf5a7D5
- >>22
専業主婦でこんな家に住めてるのになんで都民を馬鹿にせなあかんのや
余裕があるやつは他人を貶さへんのちゃうんか - 67 名前:ここからは表現の自由でイカせていただきます 投稿日時:2025/10/30(木) 14:47:31.104 ID:RgmN3Uzpi
- >>56
やることなくて暇なんやろ
町に娯楽がまともにないから桃鉄しとる - 113 名前:ここからは表現の自由でイカせていただきます 投稿日時:2025/10/30(木) 14:55:12.052 ID:KyhjQ.xdW
- >>67
桃鉄もアオキーズピザも皮肉やろ
ついでに旦那持ちも皮肉や - 70 名前:ここからは表現の自由でイカせていただきます 投稿日時:2025/10/30(木) 14:47:47.754 ID:L980bS3Qp
- >>56
SNSなんてマウントバトルする奴しかやらんし - 58 名前:ここからは表現の自由でイカせていただきます 投稿日時:2025/10/30(木) 14:45:54.036 ID:dqdTlw7cj
- >>22
すごすぎるw - 59 名前:ここからは表現の自由でイカせていただきます 投稿日時:2025/10/30(木) 14:45:54.932 ID:HO7LUxaKC
- >>22
金に目が眩んで結婚して名古屋住みになったけど、同級生の都会キラキラ生活が羨ましいから自己を正当化してるだけやね - 93 名前:ここからは表現の自由でイカせていただきます 投稿日時:2025/10/30(木) 14:51:46.475 ID:rvVoLvxwl
- >>59
今の東京って価値あるか?ワイ札幌行ったことあるけど東京となんも変わらんかったわ - 137 名前:ここからは表現の自由でイカせていただきます 投稿日時:2025/10/30(木) 15:01:05.709 ID:w1tac2VVs
- >>93
雪降って寒いというだけでゴミやろ - 165 名前:ここからは表現の自由でイカせていただきます 投稿日時:2025/10/30(木) 15:08:28.527 ID:NU6Lll2Om
- >>93
少なくとも札幌名古屋ではキラキラ主婦になれんからな - 73 名前:ここからは表現の自由でイカせていただきます 投稿日時:2025/10/30(木) 14:48:12.928 ID:WPoLcJ2Qr
- >>22
シャチホコをわざわざ飾るあたり住む地域にアイデンティティ依存しすぎやね
趣味とか始めるべき - 104 名前:ここからは表現の自由でイカせていただきます 投稿日時:2025/10/30(木) 14:53:22.986 ID:KRc6ISSTk
- >>59
>>73
東京住んでた時は地方馬鹿にしてたタイプやろなぁ - 74 名前:ここからは表現の自由でイカせていただきます 投稿日時:2025/10/30(木) 14:48:27.691 ID:esvEqV8dD
- >>22
東京脱出とか言ってる時点で未練捨てきれてない
本当に脱出した奴は住むところじゃねえと早々に見切りつけて仕事に没頭や - 99 名前:ここからは表現の自由でイカせていただきます 投稿日時:2025/10/30(木) 14:52:38.900 ID:79NLSb6Vy
- >>74
それここのウサギ小屋民も当てはまるんやないんか?
憧れの東京住みなんやから都落ちの人間の戯言なんか気にしないんやろ? - 80 名前:ここからは表現の自由でイカせていただきます 投稿日時:2025/10/30(木) 14:49:17.695 ID:h8G2T.3c5
- >>22
こいつ自分で稼いでないくせに偉そうだな - 86 名前:ここからは表現の自由でイカせていただきます 投稿日時:2025/10/30(木) 14:50:27.225 ID:Td5QFGxVR
- >>80
女ってそういう生き物やろ
旦那の力=自分の力やと勘違いする生き物なんや - 81 名前:ここからは表現の自由でイカせていただきます 投稿日時:2025/10/30(木) 14:50:04.597 ID:dqdTlw7cj
- >>22
このへんか? - 85 名前:ここからは表現の自由でイカせていただきます 投稿日時:2025/10/30(木) 14:50:18.923 ID:kF3HmkTb6
- >>22
さすがに釣りやろ - 94 名前:ここからは表現の自由でイカせていただきます 投稿日時:2025/10/30(木) 14:51:49.698 ID:Cl5QwsM1F
- >>22
ぜってーどこぞの企業の応接間やろ
生活感が無さすぎる - 98 名前:ここからは表現の自由でイカせていただきます 投稿日時:2025/10/30(木) 14:52:38.002 ID:aq9psEg.j
- >>22
これをフォローしてる奴って何が目的やねん - 108 名前:ここからは表現の自由でイカせていただきます 投稿日時:2025/10/30(木) 14:54:08.301 ID:ZAwNJU9Vl
- >>22
うさぎゅあああああ!! - 109 名前:ここからは表現の自由でイカせていただきます 投稿日時:2025/10/30(木) 14:54:21.880 ID:no7OxpV0Y
- >>22
シャチホコの趣味悪すぎるやろ - 114 名前:ここからは表現の自由でイカせていただきます 投稿日時:2025/10/30(木) 14:55:20.021 ID:USM43QdhX
- >>22
何をするにも不便そうな空間やな - 116 名前:ここからは表現の自由でイカせていただきます 投稿日時:2025/10/30(木) 14:55:26.619 ID:G1tSms7kM
- >>22
これ住所特定できちゃうやん
危機意識低いな - 131 名前:ここからは表現の自由でイカせていただきます 投稿日時:2025/10/30(木) 14:59:31.502 ID:N1Ygv16IE
- >>22
何城だよこれ
名古屋城でも犬山城でもねえなこれ - 135 名前:ここからは表現の自由でイカせていただきます 投稿日時:2025/10/30(木) 15:00:09.354 ID:.exuzXChY
- >>131
大阪城だべ - 140 名前:ここからは表現の自由でイカせていただきます 投稿日時:2025/10/30(木) 15:02:17.463 ID:Mz4xDpVEd
- >>22
旦那のステータス誇示してて可哀想 - 146 名前:ここからは表現の自由でイカせていただきます 投稿日時:2025/10/30(木) 15:03:31.064 ID:epvxaYIwc
- >>22
ワイらの“負け”や - 152 名前:ここからは表現の自由でイカせていただきます 投稿日時:2025/10/30(木) 15:04:48.718 ID:0HPyxxISc
- >>22
中日ドラゴンズの試合見に行ってそう - 160 名前:ここからは表現の自由でイカせていただきます 投稿日時:2025/10/30(木) 15:07:11.821 ID:8VAL8UDCM
- >>22
旦那凄い→私凄い - 164 名前:ここからは表現の自由でイカせていただきます 投稿日時:2025/10/30(木) 15:08:23.212 ID:dE8aQgTSm
- >>22
馬鹿みたいなシャチホコだけど名古屋県民なら納得出来てしまうわ - 23 名前:ここからは表現の自由でイカせていただきます 投稿日時:2025/10/30(木) 14:41:38.659 ID:dqdTlw7cj
- 消せ
- 24 名前:ここからは表現の自由でイカせていただきます 投稿日時:2025/10/30(木) 14:41:41.877 ID:iaBm3EEH9
- 何も無い田舎に住むよかマシ
- 25 名前:ここからは表現の自由でイカせていただきます 投稿日時:2025/10/30(木) 14:41:45.196 ID:dqdTlw7cj
- 消せ消せ
- 26 名前:ここからは表現の自由でイカせていただきます 投稿日時:2025/10/30(木) 14:41:46.739 ID:w1EtnSh48
- これ家賃いくらなん?
- 27 名前:ここからは表現の自由でイカせていただきます 投稿日時:2025/10/30(木) 14:41:52.179 ID:dqdTlw7cj
- 消せ消せ消せ
- 28 名前:ここからは表現の自由でイカせていただきます 投稿日時:2025/10/30(木) 14:41:53.301 ID:NZ64/BHQ4
- ワイ悔しいわ
- 30 名前:ここからは表現の自由でイカせていただきます 投稿日時:2025/10/30(木) 14:42:19.449 ID:h1QL6wCkh
- アフ
ィリエイトほんま覇権やな - 33 名前:ここからは表現の自由でイカせていただきます 投稿日時:2025/10/30(木) 14:42:40.368 ID:/ROhq0KJz
- エッヂにも名古屋ゲェジおるよな
- 34 名前:ここからは表現の自由でイカせていただきます 投稿日時:2025/10/30(木) 14:42:42.247 ID:dqdTlw7cj
- トンキンァァァァァァァァァァァァ!!!!!💢💢💢💢💢💢
- 35 名前:ここからは表現の自由でイカせていただきます 投稿日時:2025/10/30(木) 14:43:04.996 ID:eQazYlNiZ
- 普通シャンデリアと牛乳石鹸ピラミッド置くよね
- 36 名前:ここからは表現の自由でイカせていただきます 投稿日時:2025/10/30(木) 14:43:20.336 ID:dqdTlw7cj
- てか一番場所喰うタンス無いやん?
服もってないんか? - 37 名前:ここからは表現の自由でイカせていただきます 投稿日時:2025/10/30(木) 14:43:31.134 ID:dqdTlw7cj
- >>1
強すぎw - 40 名前:ここからは表現の自由でイカせていただきます 投稿日時:2025/10/30(木) 14:43:45.671 ID:PBKY4cxrn
- 嫌儲で同じスレある
- 41 名前:ここからは表現の自由でイカせていただきます 投稿日時:2025/10/30(木) 14:43:52.826 ID:dqdTlw7cj
- 消せ消せ消せ消せ
- 47 名前:ここからは表現の自由でイカせていただきます 投稿日時:2025/10/30(木) 14:44:34.847 ID:rFcnuOgQD
- 特定できる?
- 49 名前:ここからは表現の自由でイカせていただきます 投稿日時:2025/10/30(木) 14:44:38.882 ID:s7CKM8qoU
- 対戦型SNS定期
ありがとうイーロン・マスク - 50 名前:ここからは表現の自由でイカせていただきます 投稿日時:2025/10/30(木) 14:44:53.737 ID:Y6lpTkYkm
- それより収納が全然ないやん
- 51 名前:ここからは表現の自由でイカせていただきます 投稿日時:2025/10/30(木) 14:44:59.432 ID:LPSjtNyBz
- 言い過ぎやろ
- 52 名前:ここからは表現の自由でイカせていただきます 投稿日時:2025/10/30(木) 14:45:17.977 ID:dqdTlw7cj
- ギャオオオオオオオオオオン
- 53 名前:ここからは表現の自由でイカせていただきます 投稿日時:2025/10/30(木) 14:45:25.107 ID:dqdTlw7cj
- 消せ消せ消せ消せ消せ
- 54 名前:ここからは表現の自由でイカせていただきます 投稿日時:2025/10/30(木) 14:45:32.942 ID:dqdTlw7cj
- これは効くw
- 57 名前:ここからは表現の自由でイカせていただきます 投稿日時:2025/10/30(木) 14:45:48.660 ID:0FJduZ4Is
- なんでそんなひどいこと言うんや・・・
- 60 名前:ここからは表現の自由でイカせていただきます 投稿日時:2025/10/30(木) 14:45:57.725 ID:y0K5Ct.ex
- 全然燃えてない嫉妬イッチ定期
- 61 名前:ここからは表現の自由でイカせていただきます 投稿日時:2025/10/30(木) 14:46:16.706 ID:ocbJpR4zE
- 実際東京で就職するやつのほとんどって地方の倍率高いホワイトカラーの席から弾かれた無能やしな
- 62 名前:ここからは表現の自由でイカせていただきます 投稿日時:2025/10/30(木) 14:46:34.177 ID:cK.98v5D8
- 何このすすき
流行ってんのか - 65 名前:ここからは表現の自由でイカせていただきます 投稿日時:2025/10/30(木) 14:47:03.937 ID:SM2bvBORB
- アオキーズピザで草
- 66 名前:ここからは表現の自由でイカせていただきます 投稿日時:2025/10/30(木) 14:47:25.328 ID:Cl5QwsM1F
- 最近名古屋持ち上げ系よく見かけるけどそんなにええか?
- 68 名前:ここからは表現の自由でイカせていただきます 投稿日時:2025/10/30(木) 14:47:35.074 ID:LJgi78VbB
- 特定できるやろ
- 69 名前:ここからは表現の自由でイカせていただきます 投稿日時:2025/10/30(木) 14:47:44.086 ID:dqdTlw7cj
- 消せ消せ消せ
- 71 名前:ここからは表現の自由でイカせていただきます 投稿日時:2025/10/30(木) 14:48:01.603 ID:.QO3zCJfI
- 若くして金持ちと結婚した女がXのヒエラルキー最上位よな
ガチの金持ちはそんなXで他人煽らんけど玉の輿は精神面はガキのまんまやから - 72 名前:ここからは表現の自由でイカせていただきます 投稿日時:2025/10/30(木) 14:48:07.877 ID:dqdTlw7cj
- 消せ消せ消せ
- 76 名前:ここからは表現の自由でイカせていただきます 投稿日時:2025/10/30(木) 14:48:32.436 ID:h8G2T.3c5
- 好きでやってはんねんからほっとけよ器が小さいな
- 77 名前:ここからは表現の自由でイカせていただきます 投稿日時:2025/10/30(木) 14:49:00.909 ID:.WxmIYlAY
- 引用もいいねも一桁🤣
- 79 名前:ここからは表現の自由でイカせていただきます 投稿日時:2025/10/30(木) 14:49:16.429 ID:y0K5Ct.ex
- こんなのでも意外と効いてる奴ちらほらおって草
- 84 名前:ここからは表現の自由でイカせていただきます 投稿日時:2025/10/30(木) 14:50:18.568 ID:QkhrsGSvV
- SNSってやっぱやるべきやないなぁ
ゲェジしか湧かないやん - 87 名前:ここからは表現の自由でイカせていただきます 投稿日時:2025/10/30(木) 14:50:42.059 ID:YVvcAgj/3
- マンさんマウント大好きやな
- 88 名前:ここからは表現の自由でイカせていただきます 投稿日時:2025/10/30(木) 14:50:57.131 ID:dqdTlw7cj
- ギャオオオオオオオオオオン
- 89 名前:ここからは表現の自由でイカせていただきます 投稿日時:2025/10/30(木) 14:51:13.586 ID:jROQQVfTc
- トヨタの法務部とかほとんど弁護士しか居なそう
- 90 名前:ここからは表現の自由でイカせていただきます 投稿日時:2025/10/30(木) 14:51:25.599 ID:fL6UxCebm
- 昨日の夜のスレにも書いたけど稲だかススキ🌾置くくらいなら棚でも置けや
- 91 名前:ここからは表現の自由でイカせていただきます 投稿日時:2025/10/30(木) 14:51:25.903 ID:KRc6ISSTk
- >>1
これどこに物直すんだよホテルならええけど生活できるかよ! - 92 名前:ここからは表現の自由でイカせていただきます 投稿日時:2025/10/30(木) 14:51:45.856 ID:.3nrSbuok
- 夫のステータス=自分のステータス
カービィ理論 - 96 名前:ここからは表現の自由でイカせていただきます 投稿日時:2025/10/30(木) 14:52:13.089 ID:dqdTlw7cj
- アオキーズピザ
- 97 名前:ここからは表現の自由でイカせていただきます 投稿日時:2025/10/30(木) 14:52:25.949 ID:pcHwkkxoD
- ワイはこれぐらいがええわ
- 100 名前:ここからは表現の自由でイカせていただきます 投稿日時:2025/10/30(木) 14:52:53.150 ID:fL6UxCebm
- ベランダに出るための窓をベッドに塞いでるのがもうね
おとなしく布団敷けよ - 101 名前:ここからは表現の自由でイカせていただきます 投稿日時:2025/10/30(木) 14:53:09.614 ID:xs0y8cv8Q
- これが東京だ
- 102 名前:ここからは表現の自由でイカせていただきます 投稿日時:2025/10/30(木) 14:53:12.776 ID:dqdTlw7cj
- 消せええええ
- 103 名前:ここからは表現の自由でイカせていただきます 投稿日時:2025/10/30(木) 14:53:21.513 ID:dqdTlw7cj
- 消せええええ消せ
- 105 名前:ここからは表現の自由でイカせていただきます 投稿日時:2025/10/30(木) 14:53:35.653 ID:rvVoLvxwl
- 女呼ぶためだけのやり部屋って感じで気持ち悪い
- 106 名前:ここからは表現の自由でイカせていただきます 投稿日時:2025/10/30(木) 14:53:35.952 ID:pcT3kxyKS
- 名古屋とかに済んでる人ってどうしても「東京」に嫉妬してまうんよな
特に中途半端に上級やとそうなってまうんや
東京でこんなイベントやります!東京にこんな施設できます!みたいなニュース聞くたびに舌打ちして家が広いとか家賃が安いアピールしてしまうんや - 107 名前:ここからは表現の自由でイカせていただきます 投稿日時:2025/10/30(木) 14:54:04.289 ID:y2qcw.KhZ
- これってソファで飯食うんか
- 110 名前:ここからは表現の自由でイカせていただきます 投稿日時:2025/10/30(木) 14:54:44.479 ID:dqdTlw7cj
- 消せええええ消せ
- 112 名前:ここからは表現の自由でイカせていただきます 投稿日時:2025/10/30(木) 14:55:05.432 ID:YX.e59.BZ
- 東京脱出がアイデンティティならそらこんなこと言うわな
- 115 名前:ここからは表現の自由でイカせていただきます 投稿日時:2025/10/30(木) 14:55:20.893 ID:.QO3zCJfI
- 旦那金持ちの勝ち組女に突っかかっても敗北感味わうだけやから諦めた方がええわ
- 117 名前:ここからは表現の自由でイカせていただきます 投稿日時:2025/10/30(木) 14:55:29.455 ID:dqdTlw7cj
- 消せええええ消せ
- 118 名前:ここからは表現の自由でイカせていただきます 投稿日時:2025/10/30(木) 14:55:33.068 ID:zYu872BKj
- 東京だとそもそもこれ狭くない扱いやからな
- 120 名前:ここからは表現の自由でイカせていただきます 投稿日時:2025/10/30(木) 14:56:51.066 ID:rvVoLvxwl
- >>118
いや狭いやろ1k6畳やろこれ - 125 名前:ここからは表現の自由でイカせていただきます 投稿日時:2025/10/30(木) 14:57:54.323 ID:G1tSms7kM
- >>120
10畳はあるように見える - 119 名前:ここからは表現の自由でイカせていただきます 投稿日時:2025/10/30(木) 14:56:14.874 ID:WIDpq4.0R
- 好きでウサギ小屋住んでるんやからほっといたれや
- 121 名前:ここからは表現の自由でイカせていただきます 投稿日時:2025/10/30(木) 14:57:23.771 ID:zQF6/jQKL
- こういう性悪飼う男ってなんなんや
- 122 名前:ここからは表現の自由でイカせていただきます 投稿日時:2025/10/30(木) 14:57:24.156 ID:zal5EHY3l
- 名古屋にはチュニドラもあるからな
- 123 名前:ここからは表現の自由でイカせていただきます 投稿日時:2025/10/30(木) 14:57:35.454 ID:/nEyK4PaT
- こんな狭い部屋だけのマンションあるかよ
- 124 名前:ここからは表現の自由でイカせていただきます 投稿日時:2025/10/30(木) 14:57:36.404 ID:55sLzdTGm
- 普通、本当の金持ちなら東京で名古屋城見ながら卓上シャチホコ置くよね
- 126 名前:ここからは表現の自由でイカせていただきます 投稿日時:2025/10/30(木) 14:57:58.672 ID:Y3ZCT0tlE
- へーこいつ名古屋なんや
名古屋城見えるとこか - 127 名前:ここからは表現の自由でイカせていただきます 投稿日時:2025/10/30(木) 14:58:02.106 ID:6riT.sdlU
- >>1
プロジェクター邪魔すぎて草
部屋狭いなら短焦点にしたらいいのに - 129 名前:ここからは表現の自由でイカせていただきます 投稿日時:2025/10/30(木) 14:59:17.761 ID:rvVoLvxwl
- >>127
女ウケしか狙ってないからなこの部屋 - 128 名前:ここからは表現の自由でイカせていただきます 投稿日時:2025/10/30(木) 14:58:36.473 ID:rvVoLvxwl
- 東京 1K 家賃70000
北海道 2LDK 家賃70000
ほんまビビったわこれ
- 130 名前:ここからは表現の自由でイカせていただきます 投稿日時:2025/10/30(木) 14:59:23.117 ID:dqdTlw7cj
- 消せええええ消せ
- 133 名前:ここからは表現の自由でイカせていただきます 投稿日時:2025/10/30(木) 14:59:44.980 ID:SM2bvBORB
- 壁掛けテレビでいいやん
こんな狭い部屋でプロジェクターいるんか - 134 名前:ここからは表現の自由でイカせていただきます 投稿日時:2025/10/30(木) 14:59:52.064 ID:BasRWP80B
- 最低1LDKやわな
飯食うところにベッドがあるのが信じられん
昔のワイ社宅でもよう住んでたわ今じゃ絶対無理 - 136 名前:ここからは表現の自由でイカせていただきます 投稿日時:2025/10/30(木) 15:00:13.512 ID:3Xah9jXOK
- こういうことで争うやつってまず友達いないんよな
- 139 名前:ここからは表現の自由でイカせていただきます 投稿日時:2025/10/30(木) 15:01:52.973 ID:mCHdYUhGb
- 正直移住するにしても大阪でええよな家賃安いし
- 142 名前:ここからは表現の自由でイカせていただきます 投稿日時:2025/10/30(木) 15:02:32.468 ID:o2kppLZpn
- 虚栄心が強すぎるから都落ちだと思われたくなさすぎてマウント取ってしまう
- 143 名前:ここからは表現の自由でイカせていただきます 投稿日時:2025/10/30(木) 15:02:39.003 ID:wj/aCsyM5
- ベッドにあるのフットスローか?
要らんやろ - 144 名前:ここからは表現の自由でイカせていただきます 投稿日時:2025/10/30(木) 15:02:56.559 ID:00ZP/qMhF
- その言い方は嫉妬やろ…
- 145 名前:ここからは表現の自由でイカせていただきます 投稿日時:2025/10/30(木) 15:03:26.656 ID:xeSuFfTML
- 「まずはこれ目指そ」←これがクソキモいのでセーフ
- 147 名前:ここからは表現の自由でイカせていただきます 投稿日時:2025/10/30(木) 15:03:33.064 ID:Yn48gZx0u
- これ創価学会の事務所やん
家じゃないぞ - 159 名前:ここからは表現の自由でイカせていただきます 投稿日時:2025/10/30(木) 15:06:45.372 ID:Cl5QwsM1F
- >>147
ソースある? - 148 名前:ここからは表現の自由でイカせていただきます 投稿日時:2025/10/30(木) 15:03:34.931 ID:KPvyxUd.k
- 1kでこれは確かに必死感でるな
- 149 名前:ここからは表現の自由でイカせていただきます 投稿日時:2025/10/30(木) 15:04:01.883 ID:0pMXPop7D
- ワイの部屋東はクローゼット西は出窓南はベランダだからまるで家具おけんわ
- 150 名前:ここからは表現の自由でイカせていただきます 投稿日時:2025/10/30(木) 15:04:03.710 ID:dqdTlw7cj
- 消せええええ消せ
- 151 名前:ここからは表現の自由でイカせていただきます 投稿日時:2025/10/30(木) 15:04:33.053 ID:gh5zyZvUT
- まぁ実際金持ち以外で東京住んでるのはアホやろ
- 153 名前:ここからは表現の自由でイカせていただきます 投稿日時:2025/10/30(木) 15:06:02.170 ID:eecATsohI
- 実際わざわざ東京行って仕事見つけて家畜みたいな狭い部屋で生きてる奴って何考えてるんだ?
自分のやってることを客観視した方がいいと思う - 154 名前:ここからは表現の自由でイカせていただきます 投稿日時:2025/10/30(木) 15:06:02.552 ID:C6YY2gQ3m
- ワイが見た時引用3とかやったけど炎上なんか
- 155 名前:ここからは表現の自由でイカせていただきます 投稿日時:2025/10/30(木) 15:06:04.233 ID:DLVf0ueQ2
- 女のステータスって古今東西パートナーの男で決まるんだな
- 156 名前:ここからは表現の自由でイカせていただきます 投稿日時:2025/10/30(木) 15:06:09.236 ID:fgWf5a7D5
- 旦那の性能=男の性能って言うけど
弱男も陽キャとか強男の力を笠に着て他のやつ攻撃したりするよな
DJふぉいがどうのこうのってコムドットを貶してるチー牛を割と見た - 157 名前:ここからは表現の自由でイカせていただきます 投稿日時:2025/10/30(木) 15:06:13.653 ID:/hnqjTvlr
- 東京民が家でマウント取られるのは承知の上やろ
なんで発狂するんや? - 158 名前:ここからは表現の自由でイカせていただきます 投稿日時:2025/10/30(木) 15:06:30.312 ID:Rh6Y3UkPg
- 実家が23区じゃないなら住む意味ないやろこんな町
ワイは行くとこないからおるだけや - 161 名前:ここからは表現の自由でイカせていただきます 投稿日時:2025/10/30(木) 15:07:14.177 ID:ZH9wj/Ujc
- 閉所恐怖症やからこのレベルやとキツイな
- 162 名前:ここからは表現の自由でイカせていただきます 投稿日時:2025/10/30(木) 15:07:44.922 ID:Vp0MW9p4i
- 庭もない都内建坪25坪の家7000万で毎日満員地獄とローン地獄の中堅私大卒のワイ
一方岡山で建坪35坪に土地60坪で庭付き3500万の家購入しマイルドヤンキーやって
地元の連れや家族としょっちゅうBBQや釣りを楽しむ高卒の兄
どっちが幸せなんやと偶に思う - 168 名前:ここからは表現の自由でイカせていただきます 投稿日時:2025/10/30(木) 15:08:45.481 ID:gh5zyZvUT
- >>162
どっちが幸せかは明確だけど何に悩んでるんや - 181 名前:ここからは表現の自由でイカせていただきます 投稿日時:2025/10/30(木) 15:14:49.582 ID:obQJ1OW/m
- >>162
お前は幸せになれないぞ
お前の子供が「都内に実家がある」という最低限のスタートラインに建てる権利を7000万で買ったんや - 163 名前:ここからは表現の自由でイカせていただきます 投稿日時:2025/10/30(木) 15:08:03.378 ID:QDlNkfRMm
- こういうシーリングスポット意外と不便だから使わんほうがいい
- 166 名前:ここからは表現の自由でイカせていただきます 投稿日時:2025/10/30(木) 15:08:28.720 ID:nFM3LBZTm
- トンキンイライラで草
- 170 名前:ここからは表現の自由でイカせていただきます 投稿日時:2025/10/30(木) 15:09:10.590 ID:PZrAF.86I
- 3LDKやけどリビング布団敷きっぱなし洗濯物干し置きっぱなしやぞワイの家
- 171 名前:ここからは表現の自由でイカせていただきます 投稿日時:2025/10/30(木) 15:09:17.911 ID:3Xah9jXOK
- 軽自動車にカスタムしてるみたいな感じで見下してるんか
- 172 名前:ここからは表現の自由でイカせていただきます 投稿日時:2025/10/30(木) 15:09:29.441 ID:N1Ygv16IE
- これ名古屋城ちゃうし広い画像使ったんちゃうの
- 173 名前:ここからは表現の自由でイカせていただきます 投稿日時:2025/10/30(木) 15:09:49.343 ID:2.zAqly.B
- トンキン効いててクカ
- 175 名前:ここからは表現の自由でイカせていただきます 投稿日時:2025/10/30(木) 15:11:20.116 ID:af3UYs79i
- 別に女が旦那のステータスを誇るのは間違ってないで。
それを射止める能力がある自分を誇ってるんやから - 176 名前:ここからは表現の自由でイカせていただきます 投稿日時:2025/10/30(木) 15:11:34.606 ID:BasRWP80B
- インドアの快適性を捨ててまで東京に住んでるんだから
逆に言えば極限まで東京の娯楽を楽しまないと釣り合わないんよな
家でスマホ見てる時点で東京住むべきじゃない - 178 名前:ここからは表現の自由でイカせていただきます 投稿日時:2025/10/30(木) 15:12:43.035 ID:C8jE5Hatg
- 憧れるわこれ
秘密基地みたい
【画像】X女性「こんな風に、東京都民が狭い家で部屋を一生懸命オシャレにしてるの、見てて痛々しい」炎上www
エッヂ

コメント